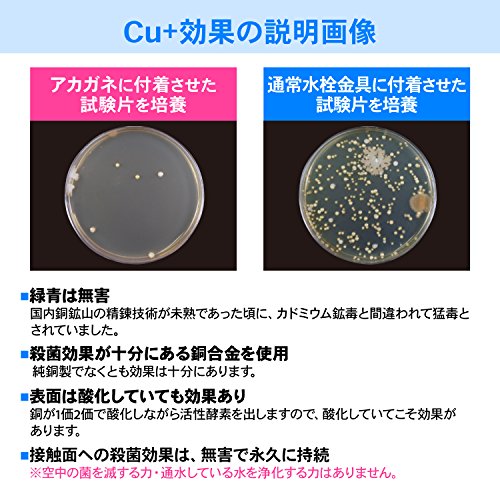

カクダイ ガーデン用水栓 アンティーク 701-316-13
¥9,004
税込
商品コード: 26023435479
関連カテゴリ
商品コード:26023435479
型番:701-316-13
701-316-13
カクダイ ガーデン専用水栓 70
01-316-13 『水栓柱・立
水栓 蛇口』 レトロ
型番:701-316-13
701-316-13
カクダイ ガーデン専用水栓 70
01-316-13 『水栓柱・立
水栓 蛇口』 レトロ
| 商品コード | 26023435479 |
|---|---|
| 商品名 | カクダイ ガーデン用水栓 アンティーク 701-316-13 |
| JAN/EAN | 4972353702565 |
| 型番 | 701-316-13 |